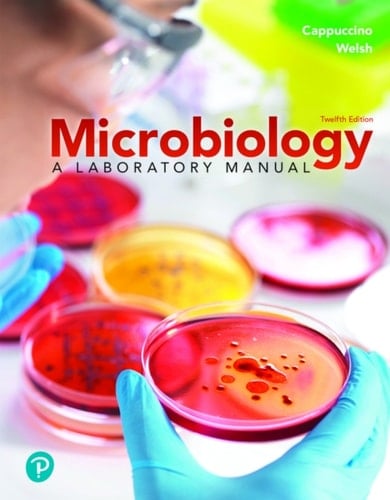
Microbiology: A Laboratory Manual (Pearson+)

Author Description
Pearson+ gives you access to much more than your eTextbook. Most titles also include audiobooks, study notes, flashcards and more to help you thrive in the classroom. For courses in microbiology lab and nursing and allied health microbiology lab. A clinical and critical-thinking emphasis Microbiology: A Laboratory Manual provides a solid underpinning of microbiology laboratory work with a strong focus on clinical applications and critical-thinking skills. The lab manual is clear, comprehensive, and versatile, and easily adapted to any microbiology lab course and paired with any undergraduate microbiology text. The 12th Edition is extensively updated to enhance the student experience and meet instructor requirements. Updates and additions include clinical case studies, equipment and material checklists, new experiments, governing body guidelines and more.
Page Count:
800
Publication Date:
2021-06-14
ISBN-10:
0137546521
ISBN-13:
9780137546527
Community Tags
Reader Comments
Share Your Thoughts
No comments yet. Be the first to share your thoughts!